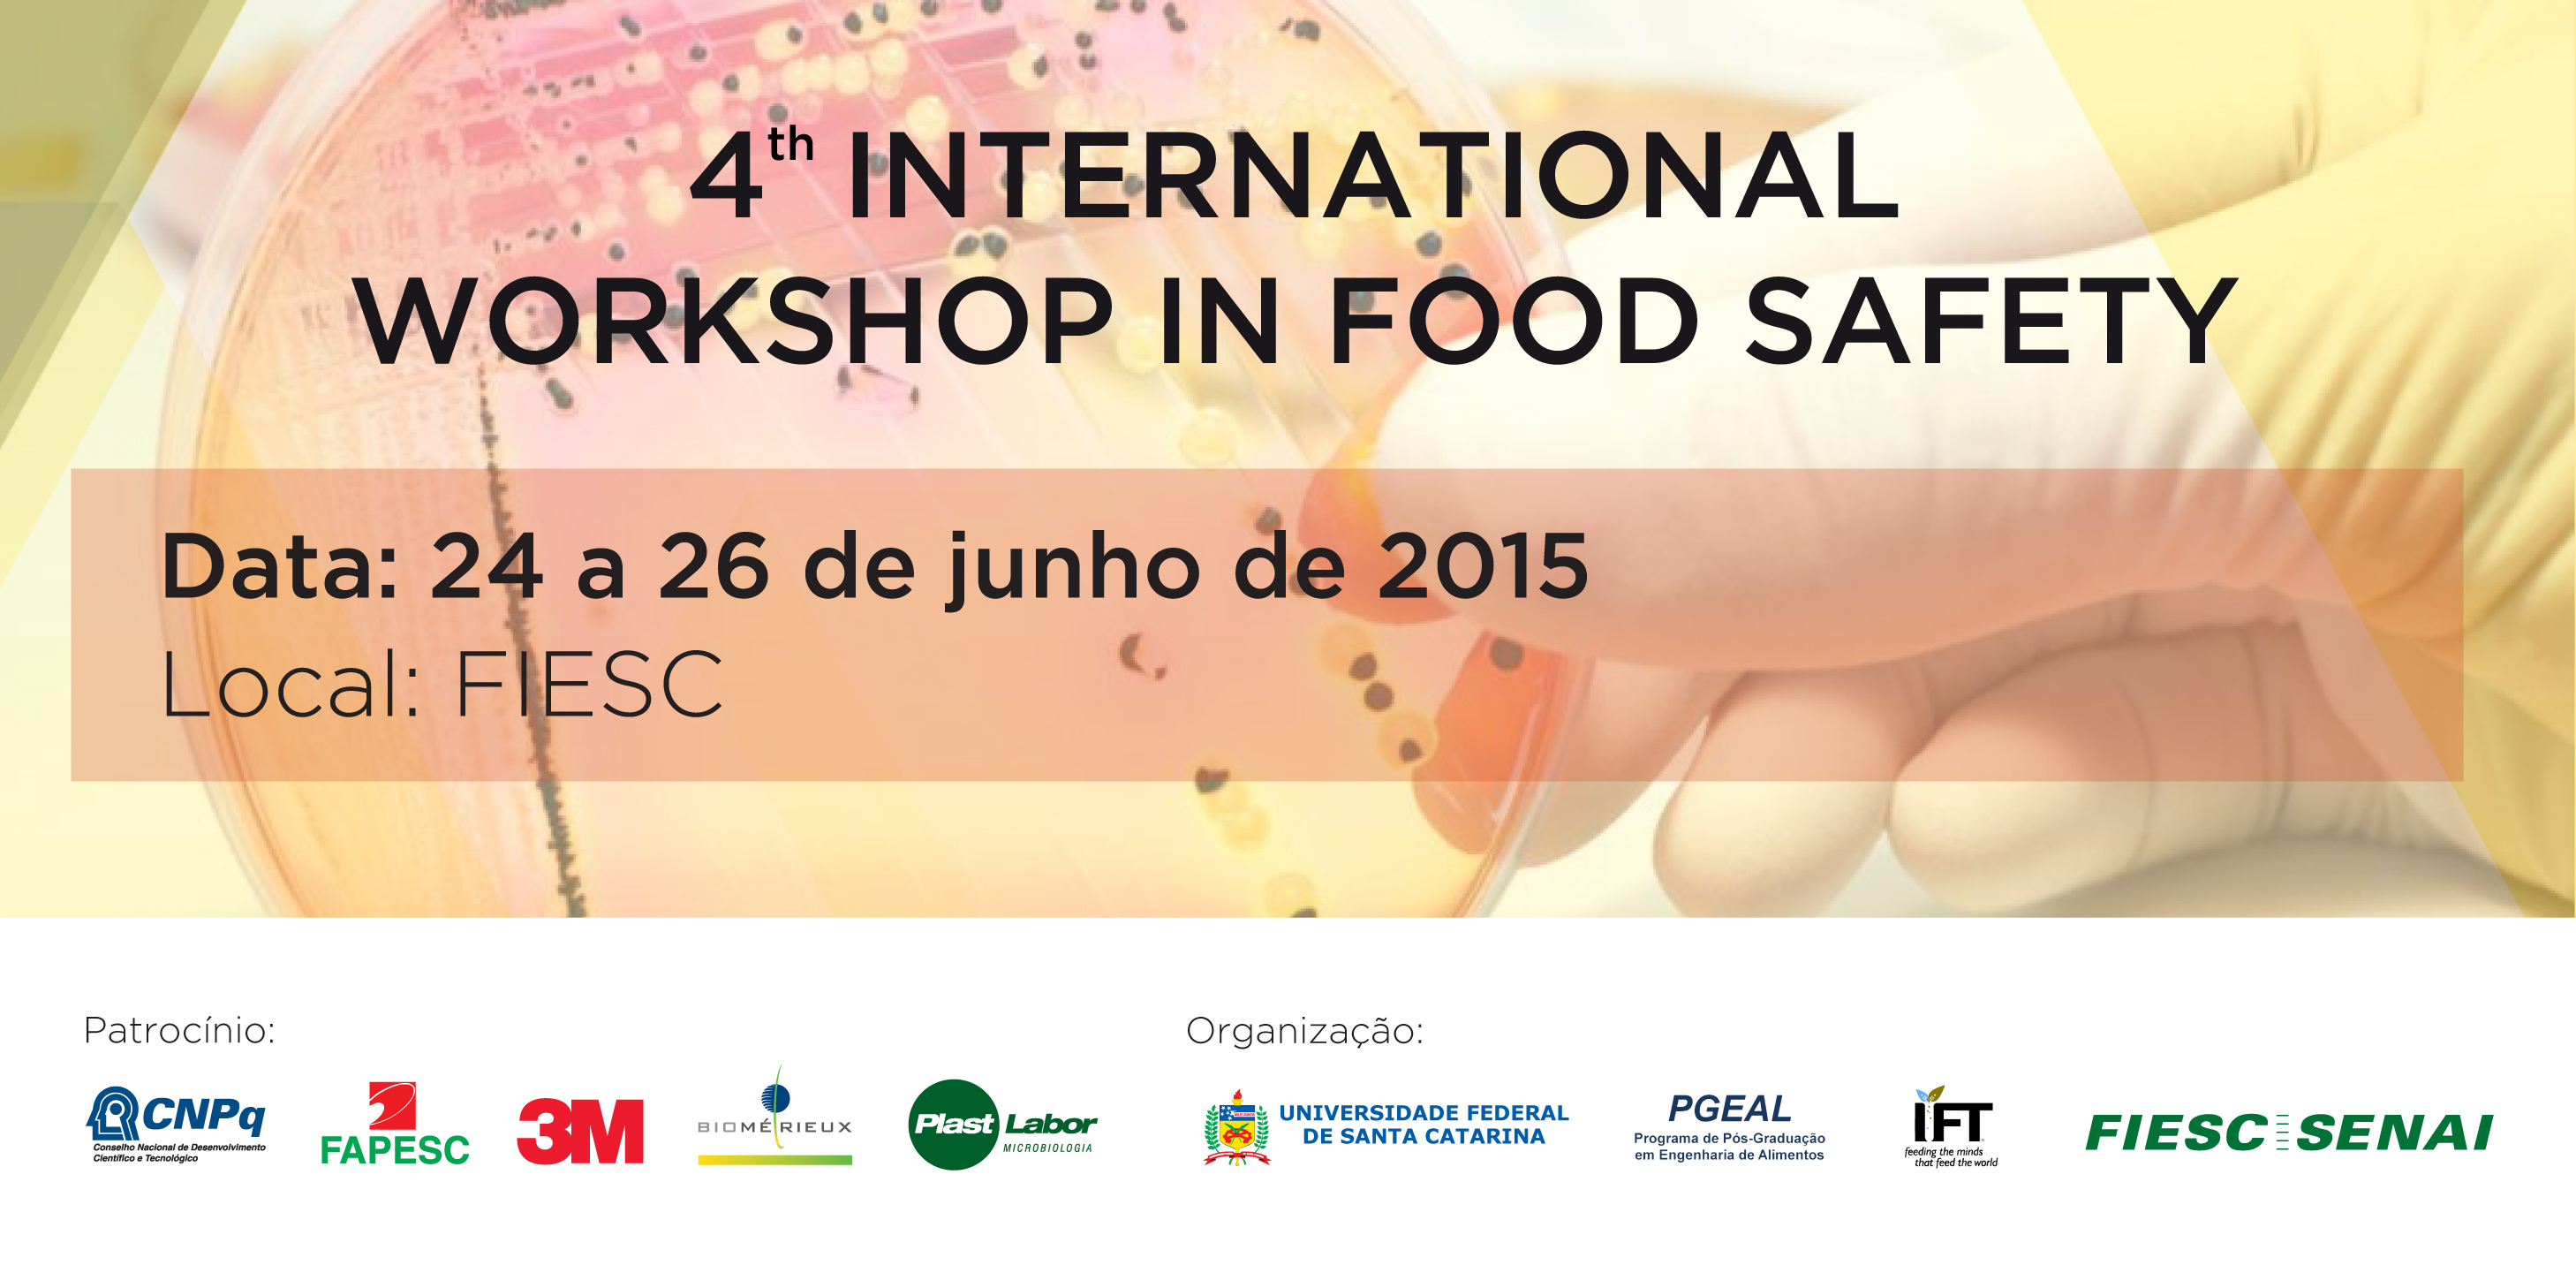
Imagem 1341 no node 3173

Florianópolis, 19.6.2015 – O SENAI/SC, entidade da FIESC, realiza dos dias 24 a 26 de junho, na sede da Federação das Indústrias, em Florianópolis, três eventos internacionais da área de segurança de alimentos. Estão previstos dois cursos e o quarto Workshop Internacional em Segurança de Alimentos, com palestrantes do Brasil, Estados Unidos, Canadá, Grécia e Itália.
O primeiro curso, dia 24, das 8 às 18 horas, será o de Extensão Profissional Premium sobre Food Defense Awaraness, que será ministrado pelos professores Neal Fredrickson e Erin Mann, da Universidade de Minnesota (EUA). Oferecido pelo National Center for Food Protection and Defense - NCFPD, um Departamento de Segurança Interna dos Estados Unidos – Centro de Excelência para Ciência e Tecnologia, este curso de um dia preparará os participantes com o conhecimento e habilidades necessários para criar programas de Food Defense robustos. Os temas em debate serão uma introdução sobre food defense até o planejamento de estruturação em food defense, incluindo uma variedade de stakeholders da indústria de alimentos, governo, aplicação de leis e academia.
O segundo curso, das 8 às 13 horas do dia 25, será sobre Predictive microbiology tools for food safety and quality, tendo como ministrantes os professores Kostas Koutsoumanis (da Universidade Aristóteles de Salonica-Grécia) e Juan Aguirre Garcia (da Universidade da Ilha de Prince Edward-Canadá). O curso oferecerá um panorama dos últimos desenvolvimentos no uso da Microbiologia Preditiva e Avaliação de Risco Microbiológico na gestão de Food Safety.
O workshop, que será realizado na tarde do dia 25 a partir das 14h30min às 18h30min e durante todo o dia 26, tratará de proteção de alimentos, comércio internacional, rastreabilidade, inspeção do FDA (agência americana de segurança de alimentos e medicamentos), entre outros temas.
Os eventos serão promovidos pela FIESC/SENAI em parceria com a UFSC e o Institute of Food Technologists – IFT (dos Estados Unidos). Mais informações e inscrições pelo site senai.sc/foodsafetyworkshop.
FIESC - Imprensa
Ivonei José Fazzioni
48 3231 4673 - 8421 3600
ivonei@fiesc.com.br